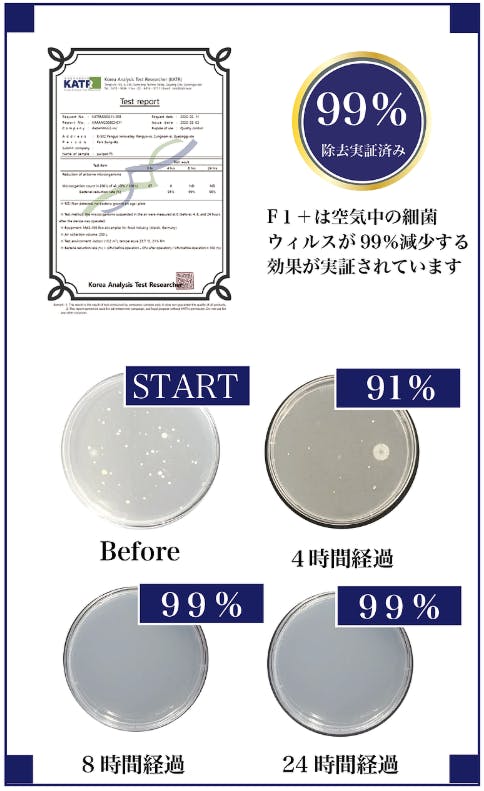

こんにちは! ご覧いただきありがとうございます。
大切な家族の空間を安全に守りたいと、今、空気清浄機について検討している方は多い
のではないでしょうか? そんな家族を思う皆さんにご紹介したいのが、
2020イノベーションアワードを受賞し、世界から注目されているPuripot F1+です!

「空気清浄機」か「除菌脱臭機」、どれがいいんだろう...
お店に並んでいるのは大型で重いのばかり...
こんなに大きいけどカバーするのは8畳までか...
フィルター交換はどれくらいコストがかかるんだろう?...
お掃除面倒そうだな...
本当にいろいろ迷いますよね。ポイントは4つです!
①安全性
これだけはお伝えしたい! 脱臭・除菌機能がついた製品は少なからず人体に有害な
「オゾン」を生じているのをご存知でしたか?
これを全く使わない製品なら大切なご家族にも安心!
②ハイパワー
③お手入れ
④デザイン
Puripot F1+は、過去に日本や海外のクラウドファンディングで500万円以上の支援を
集めたポータブル空気清浄機シリーズのハイエンドモデルです。
もとは業務用で美容サロンやホテルルームでの除菌脱臭の使用を想定している
ハイパワーさ! 韓国では大手美容サロンで一斉導入も決定しています。
それでは、特徴をご紹介します!




Puripot F1+に搭載の基本技術は光触媒。アメリカ船空宇宙局(NASA)も採用の技術です。
二酸化チタンと光源の組み合わせがポピュラーです。

※NASAはこの技術を利用し、国際宇宙ステーション内の清潔な空気環境を作っています。
詳しく知りたい方はこちらをご確認ください。
https://spinoff.nasa.gov/Spinoff2012/ee_5.html

二酸化チタンの表面に光エネルギーが当たると、空気中の水分と酸素が反応し、
OHラジカルという活性酸素を発生させます。
OHラジカルは強力な酸化分解力を持ち、シックハウスの原因物質であるVOC
(揮発性有機化合物)などの分子や細菌、ウイルス、悪臭のもとなどを
炭素と水分に分解し無害化します。

光触媒で生じるOHラジカルは除菌・脱臭の方法としてよく使われる塩素・次亜塩素酸
・オゾンなどよりはるかに強いパワーがあります。
※オゾンや塩素化合物は人体への影響が懸念されています。
このように、Puripot F1+は細菌や臭いのもとを「捕集」するのではなく、
ナノメートル粒子までのすべての有害物質・悪臭のモトを・・・「分解」します!

Puripot F1+は様々な分子や細菌を除去します。


Puripot F1+は様々な臭いのもとを除去します。


Puripot F1+なら、お部屋の状況に合わせて「壁掛け型」と「スタンド型」を選べます。
そして簡単に変えることもできます。
どんなインテリアも格上げするシンプルモダンなデザインです。

2本のネジで簡単に壁に取り付ける事ができ、3.5Kgと軽量なので女性でも簡単に
設置できます。



スタンドを取り付けるとハイセンスなインテリア風です。
スタンド脚には耐久性の高いアフリカ産の高級木材「ブビンガ」を使用しています。


※本製品は充電の機能はなくポータブルではご利用いただけません。
付属のACアダプタをご使用の上、電源供給を行ってください。

空気の質(センサー感知)によりLEDが4色に変化します。
間接照明としてもお楽しみいただけます。
※点灯する色は選べません。


明るさは5段階に調節可能です。
(OFF / 25% / 50% / 75% / 100%の明るさ)


モード(強さ)はワンタッチで5段階に調節可能です。


Puripot F1+の本体の薄さは3.6cm。重さはたったの3.5kgと女性でもラクラク持つ事
ができるサイズです。


● 革新①
人体に安全な460nm帯の青色可視光を光源に。
従来から光触媒の光源として使われている人体に有害な紫外線ゼロ
● 革新②
青色可視光でも強力に作用する二酸化チタンの特殊コーティング技術を採用
● 革新③
ハニカム構造という、蜂の巣のような形状にする事で作用面積を大きくして
ハイパワー化に成功しました。50㎡ (約30畳)まで対応します。
※メーカーが実際のテストに基づいて、脱臭効率と有効性を評価した推奨面積です。


人がオゾン含有空気を吸引することは、人体に様々な悪影響があると言われています。
また紫外線についても同様です。Puripot F1+はこのようなオゾンや紫外線を、
まったく発生・使用することなく安全に空気清浄と除菌・脱臭をする事ができます。
そして!
これまでのハイパワーなのに、お手入れが大変なフィルター交換が必要ありません。
一般の空気清浄機でフィルター交換ができずに、汚れたフィルターを使いつづけると...
①吸着した汚れにカビが発生しまう
②カビ(細菌)による悪臭が発生する
③カビ・悪臭の再放出で逆に空気を汚染してしまう。
だから! Puripot F1+は3つのゼロテクノロジーで安心・安全にご使用いただけます!

●電気代も経済的
もっとも強い Level 3(High)かつLED最大光度で使い続けても、
1時間=0.52円
24時間=12.5円
30日=375円
LED照明オフ、自動運転AUTO(推奨)ならさらにローコストになります。
※使用環境によって異なります。

●除菌試験
空気中に浮遊する微生物を、製品作動(開始)させてから、
4時間、8時間、および24時間後を測定した。
テスト環境:屋内(13.2㎡), 温度23.7℃, 湿度21%, 測定ガス200L
●脱臭試験
測定対象ガスは4種。Gastec社検知管法にて測定。可視光線光触媒がコーティングされた
不織布フィルターと対象ガスを密封し、1サイクル=120分と、同フィルター片を
そのまま操り返し使用した10サイクル後を測定した。

4種のガスすべてを120分で90~100%を脱臭。
10サイクル繰り返し使用しても脱臭機能の低下ほぼなし。
※特別な測定環境下での結果であり、実空間での試験ではありません。
効果の感じ方は、空間・個人により異なります。




CES(コンンシュマー・エレクトロニクス・ショー)は全米民生技術協会が主催する
国際的な電子家電見本市です。
Puripot F1+ は画期的な技術やデザインをもつ製品に贈られるイノベーションアワード
を受賞。その高い機能性とデザインを世界が認めています。

光触媒メッシュユニットの購入・交換は必要ありません。本体から取り外し、
清掃して元に戻すだけで継続してご使用いただけます。





場所をとらない薄型・軽量のデザインだから幅広いシーンでご使用いただけます!
● 他社製品との比較



※ ACアダプタコード長:2.0m
※ 本製品は充電の機能はなくポータブルではご利用いただけません。
付属のACアダプタをご使用の上、電源供給を行ってください。
※ 適応面積は、メーカーが実際のテストに基づいて、
脱臭効率と有効性を評価し推奨するものです。
● お届け内容





●スケジュール
2020年9月20日:プロジェクト終了
2020年11月中旬~末頃 :ご支援者様へお届け
*余裕を持ったスケジュールとしておりますが、予期せぬ理由によりお届けが遅れる
可能性もございます。その際は随時ご報告してまいります。
ご了承お願いいたします。


Dadam Micro Inc.は2000年から20年間スマートホームシステムを開発してきた
パイオニアです。私たちは韓国市場で約15万世帯に製品を提供しています。
近年新事業分野として、ヘルスケア関連の技術、製品、サービスの開発に注力し
空気清浄機のPuripot F1+はCES2020において革新的な技術とデザインで高い評価を
いただきイノベーションアワードを受賞致しました。
これは私たちの大きな喜びです。
世界の皆様に良い製品を届けるよう努力を続けています。


弊社の名前は「CIRCLE(輪・和)+COOL(素敵・格好いい)」の造語です。
世界中のすばらしいモノと、ヒトの思いを日本の皆さまにつなげることを使命として
事業を行っております。今回、除菌脱臭機【Puripot F1+】を正規輸入販売代理店として
皆様にご紹介させて頂ける事を大変うれしく思っております。
本製品に出会ったのは今年の1月7日、ラスベガスでの国際見本市CESでした。
メーカーCEOのIksoo氏はモノづくりを業とするメーカーの創業者でありエンジニア
ですが、ある時私に「すべては“モノ”ではなく”ヒト”です」と言ったことがありました。
CESで出会ったときから変わらない、いえ、きっと創業20年来 変わらない氏の人柄を
表しています。そして、その時は、この新製品がやっと量産体制に入る今春に、
世界がこのようになっているとは欠片も考えませんでした・・・
もともと業務向けを主としていたため、韓国国内での大口受注は300店舗を抱える
某大手美容サロンのフランチャイズ企業だそうです。
個人の皆さまにとって当製品が安いものではないことは承知しております。
でも素晴らしい製品です。クラウドファンディングでご紹介できる機会を通じて、
【Puripot F1+】とメーカーの思いをお一人でも多くの方にお届けできたらと
願っております。
どうぞご支援をよろしくお願い致します。

Q: フィルターの交換は、一切要らないですか?
A: フィルターはありませんので交換は不要です。
内部ハニカムモジュールは光触媒反応を起こすことで自己浄化作用があり
メンテナンスが不要です。メッシュユニットのみ水洗いか掃除機で吸い取るなど、
定期的なお手入れをお願いします。
Q: 運転音はうるさいですか?
A: 当製品はLow運転時で29dB、High運転時で49dBです。
30~50㎡に適応する製品は音量が約50dBのものが多いです。
気になる方は上記の他社製品との比較表や、下記をご参照ください。
騒音の目安について:出典「全国環境研協議会 騒音小委員会」
Q:コロナウィルス、または他のウイルスに効きますか?
A:新型コロナウィルスについては現在流行中なため、評価用の確保が難しく
"コロナウイルスの" 除去性能を測定したデータをもつ製品はかなり少ないと思います。
また当製品自体はまだ特定のウィルス除去性能のエビデンスを有しておりません。
しかし、メーカーは詳細資料(下記)で、本製品搭載技術が
インフルエンザウィルスとネコカリシウィルス(ノロウィルスの代替)に効果が
あったことを述べており、従ってほかの多くの種類のウイルスを含めた、
【ナノメートルクラスの粒子径の分子全般】に効果がある・当然コロナウィルスにも
一定の効果はあると主張しております。
エビデンスを揃えていくことは優先度の高い課題と捉え、取得を進めております。
メーカー作成の製品技術詳細資料
Q:本商品の寿命はどれくらいでしょうか?
A:製品「寿命」という仕様値はメーカーとしては持っておりません。
空間の汚染状況や湿度などの使用状況に、かなり左右されるためです。
ただご参考までに各部品については、最も強い要因はファンの寿命で、
【Level3(high=最大強度)で24時間365日、連続使用したとして】5年間です。
ただし、そのような使用をするのは稀だと思われます。その他構造的に、
主ユニットの光触媒ハニカムモジュールと、LED光源の寿命はかなり長く、
少なくとも10年以上のlifeがあります。「故障」がない限り10年以上は
十分耐久可能とのメーカーの回答となります。
Q:設置に関しては光が当たるところでないといけないのですか?
A:光が当たる場所に設置する必要はまったくありません。
光触媒に作用させる光源が、電動や太陽からの紫外線ではなく、
【人体に安全な「青色可視光」を「製品内部LEDで」創り出している技術】が、
Puripot F1+の独自の革新技術です。
真っ暗な空間(例えば睡眠中の寝室)でもしっかり作動いたします。
Q: 常時運転させた方がよいですか?
A: ご使用の環境・状態に合わせて運転モードをお選びください。
特別な必要性がないときであれば、自動運転(Auto)をお勧めします。
Q:衣類に付いている菌などの除菌はできますか?
A:Puripot F1+は、除菌物質を放出・噴霧する形ではありません。
あくまで空間中の汚染物質を含む空気を製品本体に吸い込んで、
本体内にある光触媒モジュールで作用(分解除去)され、本体からクリーンな
空気が再放出される仕組みです。ですので、普段の空気をきれいにしておくことで
カビなどの細菌予防にはなりますが、既に生じた(固形化)ものや付着した
汚染物質の分解除去はできません。
Q:1番効率の良い設置場所は、どこですか?
A:気になる臭い(タバコ・食べ物・ゴミ)や、衛生面(介護空間・ペットの居る空間)や、
住宅アレルギー物質(新しい住宅の場合の建材)など、ご個人それぞれ、
気になるもの・期待するものが異なると思いますので、最も効果を期待する場所に設置
して下さい。空気循環をよくして効果を上げるという点では、エアコン・窓・扇風機など
送風部の対角側に設置するとよいです。
Q: 日本語の説明書はついていますか?
A: はい、付いております。もしご不明な点がございましたら、いつでもお問合せ下さい。
Q: 保証はありますか?
A: リターンの発送日から1年間の保証が付きます。ただし初期不良と通常使用の場合に
限られます。落下などの事故などによる破損、製品の分解・改造などの場合は
保証の対象外となります。
●リスク&チャレンジ
※並行輸入品が発生する可能性がございます。個人輸入及び販路によって
は防ぐことができない可能性がある点、ご了承お願いいたします。
※本プロジェクトを通じて想定を上回るご支援を頂いた場合、現在進めている環境から
量産体勢を更に整えることができることにより、正規販売価格が下がる可能性がございます。
※開発中・量産体制間もない製品のため、デザイン・仕様が一部変更になる可能性がございます。
※ご注文状況、仕様部材の供給状況、製造工程上の都合等により
出荷時期が遅れる場合がございます。
※使用感等に関する返品・返金はお受けいたしかねます。
※万が一の際は上記全てにおいて、可能な限り活動レポートを共有してまいります。
<特商法に基づく表示>
販売業者:CIRCOOLE合同会社
お問い合わせ先:access@circoole.com
※こちらのメールでは当プロジェクトのお申込み・お問い合わせは受け付けておりません。
お問い合わせは当ページの「起案者にお問い合わせ」ボタンよりお願い致します。
リターン価格:当ページに記載の通り
申し込み期限:当ページに記載の通り
お支払い方法:CAMPFIREが定める支払い方法に準じます。
リターンの発送:当ページに記載の通り
最新の活動報告
もっと見るご支援ありがとうございました!
2020/09/21 21:57こちらの活動報告は支援者限定の公開です。





コメント
もっと見る